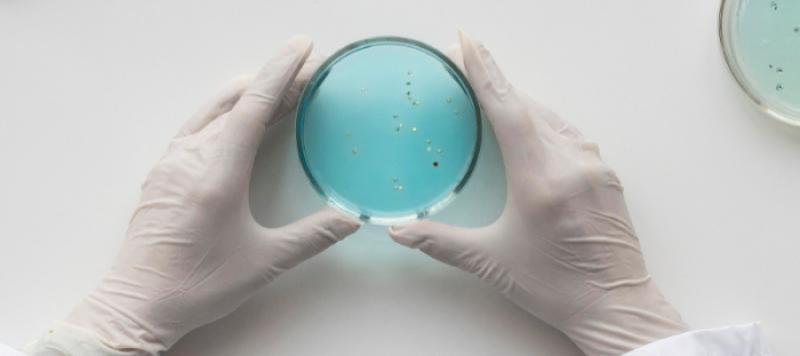
Legionella

Un estudio realizado en el Hospital Universitario de Bellvitge (Barcelona) indica que mantener la temperatura del agua caliente sanitaria (ACS) a 50°C en puntos terminales de las instalaciones hospitalarias no elimina completamente la bacteria Legionella y sugiere que aumentarla 5 grados podría reducir significativamente su presencia, ayudando a prevenir casos de legionelosis nosocomial.
Legionella en hospitales
Hasta el momento, el cultivo se mantiene como el método de referencia en el control microbiológico de Legionella en los sistemas de agua. En la normativa española, actualizada en 2022 mediante el RD 487/2022, el cultivo sigue siendo el mínimo obligatorio, aunque, con carácter complementario y en situaciones determinadas, puedan utilizarse métodos alternativos al cultivo, métodos no basados en el cultivo y métodos moleculares, en particular la PCR en directo (qPCR).
Un estudio realizado en el Hospital Universitari de Bellvitge (Barcelona) entre 2012 y 2017 cuestiona la necesidad replantear la vigilancia microbiológica de Legionella basada únicamente en el cultivo en centros hospitalarios, ya que podria ser insuficiente al no detectar la presencia de las bacterias que, bajo factores de estrés, han cambiado al estado viable pero no cultivable (VPNC).
Legionella puede cambiar su estado metabólico a VPNC bajo estrés ambiental debido a un aumento/disminución de la temperatura, variación del pH del medio o presencia de compuestos bactericidas, entre otros. Bajo estas condiciones, las bacterias pueden asentarse en biofilms o parasitar amebas para protegerse. En el estado VPNC, Legionella tiene una baja actividad metabólica y no crece en medios de cultivo, pero las bacterias conservan las características de células viables, como su integridad de membrana y virulencia.

Termotolerancia de Legionella
Por otra parte, en el estudio se analiza la persistencia y termotolerancia de Legionella en los dos sistemas independientes de ACS del hospital, estudiando la cantidad de L. pneumophila VPNC después de tratamientos térmicos.
Se constató que las mismas cepas de L. pneumophila han persistido en la red de distribución de agua caliente del hospital durante al menos seis años. Además, dado que el edificio tiene dos instalaciones independientes, un hallazgo significativo fue que una cepa diferente ha predominado en cada una de ellas. Un hecho que podría estar causado por la diferencia en la temperatura del agua caliente mantenida durante períodos prolongados de tiempo en cada instalación.
Según se establece en el RD 847/2022, para el control de Legionella en los circuitos de ACS se debe mantener la temperatura del agua por encima de 50 ºC en todos los puntos terminales del circuito y en la tubería de retorno.
Sin embargo, las autoras del estudio cuestionan la efectividad de mantener la temperatura de los sistemas de agua caliente a 50°C en los puntos más distales del sistema, tras comprobar una alta supervivencia de la bacteria.
Principales conclusiones
El estudio destaca por haber analizado tanto los estados cultivables como los VPNC de Legionella obtenidos de la red de agua caliente del hospital, estimando así el riesgo real de exposición de los pacientes a este patógeno.
Las principales conclusiones del estudio son:
- Un mismo edificio de un hospital puede estar colonizado durante períodos prolongados de tiempo con diferentes tipos predominantes de Legionella si tiene instalaciones de agua caliente independientes, por lo que los planes de gestión de riesgos para el control de Legionella en hospitales deberían considerar las características de la red de distribución.
- Los estudios de termotolerancia mediante cultivo pueden ser insuficientes. La placa de cultivo subestima la presencia de bacterias bajo factores de estrés, que han cambiado al estado VPNC.
- Mantener la temperatura de los sistemas de agua caliente a 50°C en los puntos más distales permitiría la supervivencia de más del 50% de L. pneumophila replicativa durante 24 horas. El aumento de cinco grados en estos puntos podría reducir la presencia de Legionella en más del 25%.
Según las autoras, analizar la presencia de Legionella según el único método obligatorio requerido por la legislación española actual subestima la presencia del patógeno en una instalación. Aumentar cinco grados la temperatura en los puntos más distales de los circuitos de agua caliente ayudaría a prevenir casos de legionelosis nosocomial. Una revisión de la legislación actual sería, pues, una inversión a favor de la salud de los ciudadanos, especialmente para las personas altamente vulnerables.
Por último, se considera necesaria más investigación para conocer el alcance y las implicaciones de los estados VPNC de Legionella dentro de los sistemas de agua de los hospitales, un fenómeno que puede tener implicaciones para los planes de gestión de riesgos de Legionella en aquellos hospitales que evalúan y ajustan sus medidas de control basándose en la vigilancia microbiológica.
Referencia bibliográfica
Parraga-Niño, Noemí and Cortès-Tarragó, Roger and Quero, Sara and García-Núñez, Marian and Arqué, Elisenda and Sabaté, Sara and Ramirez, Dolors and Gavaldà, Laurà, Persistence of Viable But Nonculturable Legionella Pneumophila State In Hospital Water Systems: A Hidden Enemy?. SSRN, http://dx.doi.org/10.2139/ssrn.4732237